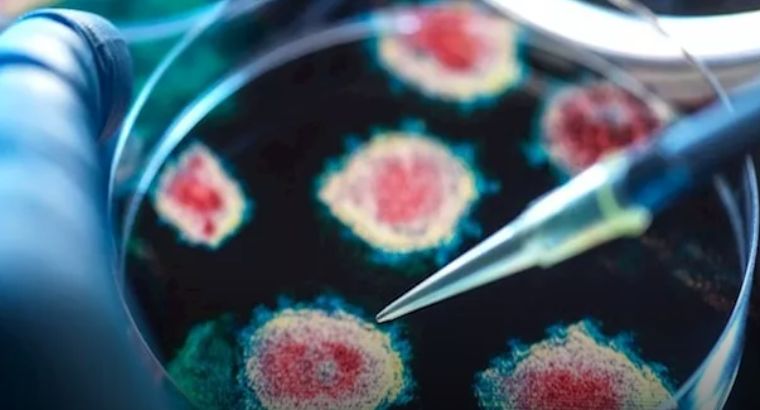
فيروس كورونا جديد.. تحذير عالمي من تهديد وبائي محتمل

شكرا لقرائتكم خبر عن فيروس كورونا جديد.. تحذير عالمي من تهديد وبائي محتمل والان مع التفاصيل
عدن - ياسمين التهامي - كشفت دراسة حديثة نُشرت في مجلة Nature Communications عن خطر متزايد يهدد الإنسان جراء فيروسات خفافيش تُعرف باسم "HKU5"، التي تنتمي إلى نفس عائلة فيروس كورونا المسبب لمتلازمة الشرق الأوسط التنفسية (MERS-CoV)، بحسب ما نقله موقع India Today.
ووفقًا للباحثين من جامعات بارزة، منها جامعة ولاية واشنطن ومعهد كاليفورنيا للتكنولوجيا، فإن هذه الفيروسات أظهرت مؤشرات على قدرتها المحتملة على اختراق الخلايا البشرية عبر مستقبل ACE2، وهو ذات المستقبل الذي يستخدمه فيروس كوفيد-19، ما يثير القلق بشأن احتمال انتقالها إلى البشر مستقبلاً.
طفرة بسيطة قد تنقلها للبشر
ويحذر الدكتور مايكل ليتكو، عالم الفيروسات والمشرف على الدراسة، من أن هذه الفيروسات لم يتم دراستها بشكل كافٍ، إلا أنها تمتلك خصائص بنيوية تجعلها قادرة نظريًا على إصابة الإنسان، خاصة وأن بعض سلالاتها أصابت بالفعل حيوانات المنك في الصين، مما يدل على قابليتها للانتقال بين الأنواع.
الذكاء الاصطناعي يكشف المخاطر
اعتمد الباحثون على تقنية AlphaFold 3 المدعومة بالذكاء الاصطناعي لمحاكاة تفاعل بروتين "سبايك" الخاص بالفيروس مع مستقبلات ACE2 البشرية، وأظهرت النتائج تطابقًا كبيرًا مع التجارب المعملية التقليدية، مما يعزز من مصداقية التحذيرات.
احتمالات الوقاية قائمة
كما أظهرت تجارب أجراها فريق صيني بقيادة العالِمة شي زينغلي، الشهيرة بلقب "المرأة الخفاش"، أن فيروس HKU5-CoV-2 قادر على إصابة الخلايا البشرية، خصوصًا في أنسجة الجهاز التنفسي والجهاز الهضمي.
في الوقت ذاته، تم رصد عدد من الأدوية والأجسام المضادة التي قد تكون فعالة ضد هذا النوع من الفيروسات، وهو ما يمنح الأمل في إمكانية الوقاية المبكرة، في حال تحور الفيروس واكتسب القدرة على الانتشار الواسع.
